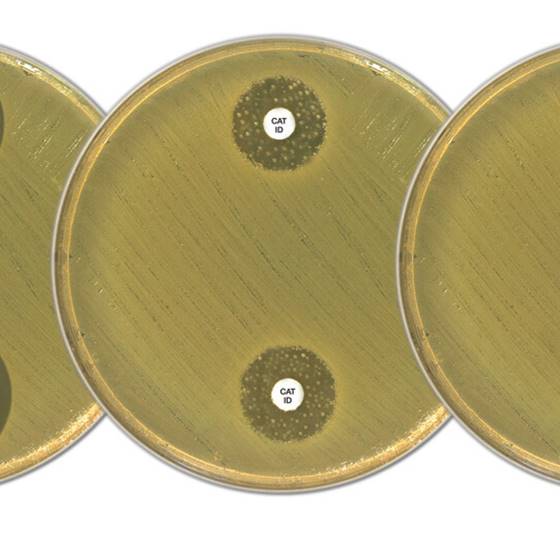

Über das Produkt
Antibiotika-Empfindlichkeitstestung (Faropenem-Testblättchen) zum Nachweis von Carbapenemase-Enzym- Produktion in Enterobacterales.
Produkte
Mikrobiologie
ESBL, AmpC und Carbapenemase Kits
Carbapenemase Aktivitätstest (CAT) D71C
Carbapenemase Aktivitätstest (CAT) D71C
Antibiotika-Empfindlichkeitstestung (Faropenem-Testblättchen) zum Nachweis von Carbapenemase-Enzym- Produktion in Enterobacterales.